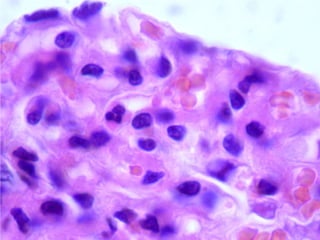

El riñón está compuesto de nefronas que filtran la sangre para producir orina. Cada nefrona contiene un corpúsculo renal con un glomérulo y una cápsula de Bowman, y varios segmentos de túbulos. La orina se forma a través de la filtración en el glomérulo y la reabsorción y secreción a lo largo de los túbulos. El riñón también regula la presión arterial a través del sistema renina-angiotensina-aldosterona.